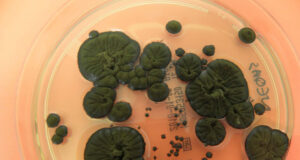

ARTIKEL LAINNYA
Mengapa Mata Kita Mirip Ayah tapi Rambut Mirip Ibu? Menguak Rahasia...
Pernahkah Anda bertanya-tanya mengapa Anda memiliki bentuk hidung yang sama dengan ayah, tetapi warna kulit lebih mirip dengan ibu? Atau mengapa dua orang tua...
Klasifikasi Inang, Vektor, dan Agen Penyakit dalam Parasitologi
Dalam ekosistem biologis, interaksi antarorganisme tidak selalu bersifat simbiosis mutualisme yang saling menguntungkan. Terdapat sisi gelap dari interaksi ini yang dikenal sebagai parasitisme. Parasitologi,...
Peran Inang dan Vektor dalam Rantai Penularan Penyakit
Dalam lanskap epidemiologi global, penyakit menular yang melibatkan perantara organisme lain (vektor) menyumbang beban kesehatan yang signifikan, mencapai lebih dari 17% dari semua penyakit...
Organisme Chernobyl, Evolusi Super Cepat
Zona Eksklusi Chernobyl (CEZ)—zona terlarang yang ditaburi radiasi sejak ledakan reaktor tahun 1986—seharusnya menjadi kuburan biologis. Namun, hampir 40 tahun kemudian, tempat ini justru...